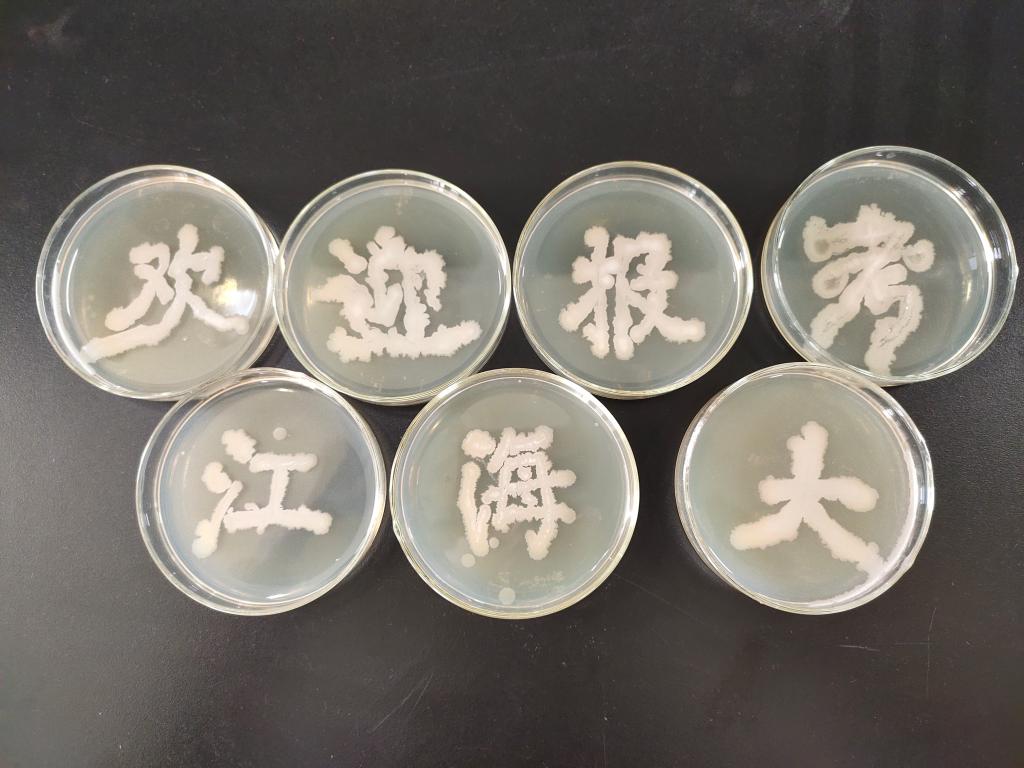

6月9日下午4时30分,生命-海洋协会举办的第三届微生物平板大赛在bevictor伟德苍梧校区海洋南楼301顺利举行。本次活动由学术组顾梓蕴主持,出席本次活动人员有bevictor伟德生物科学与技术系主任王淑芳、副主任马静,海协会长严俊杰、工作人员以及相关参赛选手。
活动伊始,由王淑芳讲解微生物实验室注意事项:在接种过程中若发生酒精泼洒要及时用湿抹布盖除,在挑取菌种的过程中要尽量避免杂菌污染以及接种环的具体使用说明。紧接着,马静给我们讲解了相关的微生物知识、比赛规则和题材建议。通过两位老师的讲解,我们对本次活动细则和实验室规范操作有了更深入的了解。
随后,主持人宣布比赛开始,选手们立刻聚精会神地投入到比赛当中,在工作人员的指导下,创作出各式各样极具创造性、图案精美的作品。
此次活动在全国海洋宣传日的背景下举行,不仅激发了同学们对生物实验的浓厚兴趣,还使同学们学习到了丰富的海洋微生物知识。同时活动结合了以海洋为主题的创作,促进了海洋文化的传播,让大家进一步地关注海洋,热爱海洋。